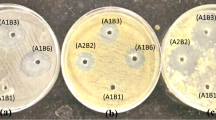

Abstract
This paper presents a comparative study of endophytic bacteria from cultivated (Oryza sativa) and wild rice (Oryza rufipogon) plants and their functional traits related to plant growth promotion. A total of 70 bacterial isolates were characterized by both biochemical and molecular identification methods. Taxonomic classification showed dominance of three major phyla, viz, Firmicutes (57.1%), Actinobacteria (20.0%) and Proteobacteria (22.8%). Screening for in vitro plant growth-promoting activities revealed a hitherto unreported endophytic bacterium from wild rice germplasm, Microbacterium laevaniformans RS0111 with highest indole acetic acid (28.39 ± 1.39 µg/ml) and gibberellic acid (67.23 ± 1.83 µg/ml) producing efficiency. Few other endophytic isolates from cultivated rice germplasm such as Bacillus tequilensis RHS01 showed highest phosphate solubilizing activity (81.70 ± 1.98 µg/ml), while Microbacterium testaceum MKLS01 and Microbacterium enclense MI03 L05 showed highest potassium (53.42 ± 0.75 µg/ml) and zinc solubilizing activity (157.50%). Fictibacillus aquaticus LP20 05 produced highest siderophore (64.8%). In vivo evaluation of plant growth-promoting efficiencies of the isolates showed that Microbacterium laevaniformans RS0111, Microbacterium testaceum MKLS01 and Bacillus tequilensis RHS 01 could increase rice grain yield by 3.4-fold when compared to the control group. This study indicates the potentiality of rice endophytes isolates as an effective bioinoculants.
Similar content being viewed by others
Avoid common mistakes on your manuscript.
Introduction
Endophytes are the microorganisms which colonize the plant tissue for a part of their life-cycle sharing numerous characteristics essential for plant growth promotion (Tan and Zou 2001; Hiruma et al. 2016; Das et al. 2019). Microbial community profiling through culture-dependent and culture-independent approaches has revealed active association of endophytic microorganisms with different plant parts including roots, stems, leaves, seeds, fruits, tubers, ovules and nodules. As a part of the rhizospheric community, distribution and diversity of endophytic bacteria are mostly influenced by host plant, soil properties and environment (Timm et al. 2018). Living within the plant tissues gives endophytic bacteria an added advantage of exerting beneficial effects directly to the host plant (Strobel et al. 2004; Rosenblueth and Martínez-Romero 2006). Diverse endophytic bacterial genus such as Azoarcus, Agrobacterium, Bacillus, Burkholderia, Enterobacter, Gluconobacter, Klebsiella, Pseudomonas, Pantoea have been reported for their plant growth-promoting traits (Bacon and Hinton 2007; Kandel et al. 2017). Several studies also showed how association of endophytic bacteria can promote growth in plants such as wheat, rice, canola, potato, tomato and many more (Sturz et al. 1997; Mei and Flinn 2010).
Endophytes promote plant growth by facilitating the acquisition of mineral resources such as phosphorus, potassium, zinc and iron which are usually less bioavailable. Endophytic microbial population also produces or stimulates phytohormone production including auxin, gibberellin and cytokinin (Rosenblueth and Martínez-Romero 2006; Glick 2014). These sets of bacteria are usually host-specific which origin in rhizosphere and find their way to the host tissues in response to specific root exudates and colonizes for ecological advantages. In addition to rhizosphere, few endophytes also originate in the seeds which after germination and seedling growth can help the endophytes in propagating to different parts of the plant (Shahzad et al. 2018). In addition to the growth promotion, endophytic bacteria can also protect the host plant by antagonistic activity (antibiosis, lytic enzyme production, allelochemicals) or by inducing systemic acquired resistance (SAR) against different phytopathogens (Pillay and Nowak 1997; Arnold 2007; Beneduzi et al. 2012). There are nearly 300,000 plant species on the earth, each of which is a host to one or more endophytes, only a few of these plants have ever been thoroughly studied relative to their endophytic biology (Strobel et al. 2004). Thus, the probability of finding novel and beneficial endophytic microorganisms from the diverse flora of ecological hotspots is considerably high. The state of Assam (India) is located within the Indo-Burma biodiversity hotspot and a secondary crater of origin forrice (Oryza sativa). Assam has more than 4000 accessions of rice germplasm (Travis et al. 2015). Along with the cultivated rice varieties, Assam also houses a significant number of wild accessions mainly belonging to Oryza rufipogon (Choudhury et al. 2013). Oryza rufipogon is basically an invasive and wild ancestor of modern rice with evolutionary significance. One facet of the “plant-soil feedback hypothesis” highly suggests that invasive plants may change or manipulate soil microbial community to its own advantage (Klironomos 2002). Such manipulation can be achieved through the facilitation of strong mutualism (Sun and He 2010). Therefore, a comparative assessment of the endophytic microflora population associated with wild and cultivated Oryza species will provide a unique opportunity to widen our understanding of how endophytic bacteria differ in both the plant environments and affect the growth of the host plants. The potential of wild-rice endophytic community with promising eco-physiological traits can be prospected for the development of an efficient bioinoculum targeting various biotic and abiotic stress environments. This study was undertaken to evaluate and compare the endophytic community in wild as well as cultivated rice varieties through culture-dependent approaches and to characterize the potential endophytes for their plant growth-promoting traits.
Materials and methods
Isolation and characterization
Locally cultivated rice varieties viz., Kola Joha, Miatong, Barjahi, Manipuri Black Rice and Gitesh were collected at booting stage from Jorhat (26°43′03.8′′N 94°11′40.2′′E), Tinsukia (27°20′34.5′′N 95°42′33.2′′E) and Lakhimpur (26°57′38.5′′N 93°51′53.5′′E) districts of Assam (Supplementary file: S2) (Sample size: 67 plants). In addition to cultivated plants (Oryza sativa), different morphotypes of wild rice viz. Oryza rufipogon, locally known as “Uri-Dhol” were collected. Healthy and disease-free paddy samples were selected, uprooted from rice fields and immediately transported to the laboratory in ice boxes. The plant samples were thoroughly cleaned under running water to remove the attached debris. Leaves, stems, and roots were separated and cut into thin sections of 2–3 cm long and washed thoroughly with double distilled water. The samples were then rinsed in 70% ethanol, sterilized with 0.1% HgCl2 and further washed with sterile distilled water several times to remove the surface sterilizing agents (Gagné et al. 1987). One gram of each sample was homogenized in 10 ml of distilled water to prepare a stock solution of the tissue homogenate. The appropriately diluted sample was inoculated in Tryptic Soya Agar (TSA) plates and incubated at 30 °C for 48 h and pure cultures were isolated by streak plate method with three subsequent streaks. The bacterial isolates were characterized both morphologically and biochemically through various tests viz. Gram’s staining, starch hydrolysis, casein hydrolysis, catalase reaction, citrate and malate utilization, nitrate reduction, H2S production and gelatine liquefaction with accordance to the Bergey’s Manual of Determinative Bacteriology (Bergey 1974). The detailed procedures for the tests are mentioned in the Supplementary file S1.
Molecular characterization
Genomic DNA was extracted from bacteria as per standard phenol–chloroform method. The 1600 bp region of the 16S rRNA gene was amplified from the extracted genomic DNA using the universal forward primer 5′-AGAGTTTGATCCTGGCTC-3 (27F) and reverse primer 5′-AAGGAGGTGATCCAGCCG-3′ (1492 R). The PCR products thus obtained were sequenced using capillary sequencer. Forward and reverse sequences obtained were assembled using the Codon Code Aligner software (v 5.0). Nucleotide sequence identities were determined by subjecting the assembled consensus sequence to EzTaxon server (Yoon et al. 2017). A phylogenetic tree was constructed using MEGA 6.0 based on neighbor-joining method for the analysis of evolutionary relatedness and the evolutionary distances were computed using the Kimura 2-parameter (Kimura 1980). For this, sequence similarity tool BLAST (Altschul et al. 1990) was employed against “16S ribosomal RNA sequence (Bacteria and Archea)” database of NCBI to retrieve 16S rRNA gene sequences from related taxa. Partial sequence data (1300–1500 bp) for the 16S rRNA genes were deposited in the GenBank nucleotide sequence data libraries and GenBank accession numbers were obtained.
Determination of species diversity
Diversity and relative species abundance of the endophytic isolates were calculated using Shannon diversity index and Simpson diversity index. Species richness was studied using rarefaction curve (Hammer et al. 2001). Past software v3.0 was used to calculate the diversity indices and to produce the rarefaction curve.
Plant growth-promoting traits
Phytohormone production
Indole acetic acid (IAA) production
For the quantitative estimation of IAA, the bacterial isolates were cultured overnight in minimal salt (DFMS) media (DWORKIN and FOSTER 1958). 20 μl of culture aliquots were transferred into 5 ml of DFMS media amended with filter sterilized l-tryptophan (1000 μg/ml). After incubation at 30 °C for 72 h, the culture was centrifuged at 5500 × g for 10 min. For measuring the amount of IAA produced, 1 ml of culture supernatant was mixed with 4 ml of Salkowski reagent (150 ml concentrated H2SO4, 250 ml of distilled H2O, 7.5 ml 0.5 M FeCl3.6H2O solution). Development of pink colour indicates the production of IAA. After 20 min optical density was taken at 535 nm by UV–Vis spectrophotometer (Spectroquent Pharo300, Merck Millipore, India). The concentration of IAA produced by cultures was measured with the help of a standard graph of IAA obtained in the range of 10–100 μg/ml (Patten and Glick 2002).
Gibberellic acid (GA) production
For the determination of gibberellic acid, fresh bacterial cultures (1 ml of 0.6 OD) were inoculated into nutrient broth modified with l-tryptophan (1000 μg/ml) and incubated at 30 °C for 72 h. 5 ml of the supernatant was taken in a test tube to which 0.4 ml of zinc acetate was added. After 2 min of incubation at room temperature, 0.4 ml of potassium ferrocyanide was added and centrifuged at 1000 rpm for 15 min. The supernatant was collected and 3 ml of 30% HCl was added and incubated at 20 °C for 75 min. The control sample was treated with 5% HCl and the absorbance of the sample was measured at 254 nm in a UV–Vis spectrophotometer (Paleg and Coombe 1967). Amount of GA present in the extract was calculated from standard curve and expressed as μg/ml of the medium.
Mineral solubilization
Phosphate solubilization
Phosphate solubilization was screened by Pikovskaya’s agar plating method as described by Gaur 1990. Inoculated plates were incubated at 30 °C for 72 h and a formation of clear halo zone showed positive isolates for the production of phosphatase. Quantitative analysis of phosphate solubilisation was performed by inoculating the test isolates in 25 ml Pikovskaya’s broth and incubated for 2 days at 30 °C (Jackson 1973). The bacterial cultures were centrifuged at 10,000 rpm for 10 min. One ml of supernatant was mixed with 10 ml of chloromolibidic acid and the volume was made up to 40 ml with distilled water. One ml cholorostannous acid was added and the volume was made up to 50 ml with distilled water. The absorbance of the developing blue colour was measured at 600 nm wavelength with UV–Vis spectrophotometer. The amount of soluble phosphorus was quantified from standard curve of KH2PO4.
Potassium solubilization
Potassium solubilizing efficiency of the isolates was tested on Aleksandrov’s medium with 0.2% (w/v) potassium aluminum silicate (Hu et al. 2006). Isolates showing a clear zone around the colony (as a result of potassium solubilization) were considered as positive and were further subjected to quantitative estimation. Quantification of phosphate solubilization was done by inoculating positive isolates into 40 ml of Aleksandrov’s broth culture media and incubating for 5 days at 30 °C and 140 rpm rotation. After incubation broth was centrifuged at 10,000 rpm for 10 min. The 5 ml supernatant of each sample was taken in a test tube and 5 ml sodium cobaltinitrite solution was added. The reaction mixture was incubated at 37 °C for 45 min to precipitate to settle down in the tube. The supernatant was decanted, precipitated and collected and washed twice with distilled water and once with absolute alcohol. After careful washing, 10 ml of concentrated HCl was added to the precipitate and incubated at 37 °C for 15 min for colour development and absorbance was measured at 623 nm. Different concentrations of KCl solution, ranging from 0 to 100 μg/ml were used for the preparation of standard curve.
Zinc solubilization
For detection of zinc solubilization, freshly cultured bacterial isolates were spot inoculated on tris minimal agar medium modified with Zinc oxide (ZnO) at a concentration of 0.1% and incubated at 30 °C. After 72 h of incubation, clear halo zone formation was observed in the positive isolates capable of solubilizing zinc. The solubilization efficiency (SE) was calculated by the formula:
The isolates with the highest SE are considered to be effective zinc solubilizers (Ramesh et al. 2014).
Siderophore production
Bacterial isolates were assayed for siderophore production on Chrome azurol S agar medium (Schwyn and Neilands 1987). Bacterial cultures were spot inoculated in Chrome azurol S agar plates and incubated at 30 °C for 48–72 h. Development of yellow/orange halo around the growth was considered positive for siderophore production.
Quantitative estimation of siderophores was done by CAS shuttle assay (Payne 1994). Positive isolates were inoculated in iron-free succinic acid (SM) medium consisting of K2HPO4, 6 g; KH2PO4, 3 g; MgSO4.7H2O, 0.2 g; and succinic acid, 4 g in 1 l, pH 7.0, and incubated for 24–30 h at 29 °C with constant shaking at 120 rpm. Following incubation, the broth was centrifuged at 10,000 rpm for 15 min. The supernatant (0.5 ml) was mixed with 0.5 ml of CAS reagent, and absorbance was measured at 630 nm against a reference consisting of 0.5 ml of un-inoculated broth with 0.5 ml of CAS reagent. Siderophore content was calculated by using the following formula:
\(\% {\text{ of Siderophore unit = }}\frac{{{\text{Ar}} - {\text{As}}}}{{{\text{Ar}}}} \times 100,\)where Ar = absorbance of reference at 630 nm (CAS reagent) and As = absorbance of the sample at 630 nm.
Efficacy of bioinoculum on plant growth promotion under greenhouse conditions
Plant materials
A short duration rice variety of Assam, Dichang was used for the pot culture study. The variety is cultivated in the Sali (June/July to November/December) and Boro (November/December to May/June) season. The rice variety was collected from the Assam Agricultural University (Assam Agricultural University; Accession number: AAU RRSDS76522).
Inoculum preparation
Bacterial isolates viz., Microbacterium laevaniformans RS0111, Bacillus tequilensis RHS01 and Microbacterium testaceum MKLS01 which had shown the highest phytostimulant activities were selected for pot culture experiment. Selected isolates were cultured overnight in nutrient broth (NB medium) at 30 °C to an OD value of 0.5 at 600 nm. The consortium was prepared by mixing 100 ml of each culture prior to application. The compatibility of isolates was checked prior to the preparation of consortia (Fukui 1994).
Experimental design
The experiment was arranged in a complete randomized design (CRD) with five replications per treatment. Six different treatments with compositional differences in bioinoculum, organic compost (vermicompost) and inorganic fertilizers were set up. A control set of pot was maintained without any treatment to replicate the controlled environment. Treatments designed were T0: soil (untreated); T1: soil + chemical fertilizer (NPK); T2: soil + vermicompost; T3: soil + bioinoculum; T4: soil + vermicompost + bioinoculum; T5: soil + ½ NPK + ½ vermicompost; T6: soil + ½ NPK + ½ vermicompost + ½ bioinoculum.
Pot preparation
Soil from rice fields was collected, air-dried, sieved and sterilized by repeated (3 times) autoclaving. Chemical fertilizer Nitrogen, Phosphorus, and Potassium (NPK) were used in a ratio of 40:20:20 kg/hectare. Vermicompost was used in a ratio of 300 gm/10 kg of soil. In bioinoculum treatment, each pot (pot size = 10 kg) received 20 ml of bacterial inoculum.
Seed sowing and harvesting of the plants
Rice seeds were soaked in sterilized water in a Petri dish for 24 h. The water was drained off and the seeds were kept in a closed Petri dish in warm conditions for 2 days. Four pre-germinated seeds were allowed to grow in each pot in the greenhouse. The plants were watered twice a day to maintain optimum soil moisture regime (40%). The plants were regularly monitored till harvest (150 days). Parameters selected for assessing the growth of the plant were plant height, number of tillers, number of leaves per tiller, length of the flag leaf, number of panicles per tiller, the total number of seeds per plant, weight of 100 grains, weight of dry biomass and yield per plant were measured from 30 days till harvest in an interval of every 15 days.
Statistical analysis
Data from the quantitative analysis of plant growth-promoting traits and pot culture experiment were analyzed by one-way analysis of variance (ANOVA). Statistical analysis was performed using SPSS software (version 18). Significant differences between means were compared using the least significant differences test (LSD) at 5% (p ≤ 0.05) probability level.
Results
Isolation and characterization
A total of 255 potential bacterial endophytes were isolated from leaf, stem and root section of both cultivated and wild rice plants. About 70 different isolates were selected on the basis of varying morphological characteristics. Gram’s staining revealed that out of these 70 isolates, 53 isolates were Gram positive, while 17 were Gram negative. Thirty-three isolates were found to be positive for starch hydrolysis (amylase producers), 15 isolates were positive for casein hydrolysis (protease producers), 41 isolates were catalase producers, 14 citrate utilizers, 35 malate utilizers, 22 nitrate reducers, 33 H2S producers and 46 gelatinase producers (Table S1).
These isolates were further characterized at the molecular level using 16S rRNA gene sequence data (Table 1). A phylogenetic tree was constructed using the 16S rRNA gene sequences and the evolutionary relatedness was inferred using the Neighbor-Joining method. The bacteria isolated in this study belonged to three major phyla, viz., Firmicutes (57.1%), Actinobacteria (20.0%) and Proteobacteria (22.9%). Phylogenetic distribution study showed that the isolates from cultivated and wild rice grouped in same phylogeny clusters (Fig. 1). Gram-positive bacteria and Gram negative formed two major independent clusters, Cluster I and Cluster II, respectively. The Cluster I included two phyla viz. Firmicutes and Actinobacteria, while Cluster II comprised of phylum, Proteobacteria. Within the Firmicutes, major clade belonged to the class Bacilli mainly encompassing the genus Bacillus (92.5%) and Actinobacteria (7.5%). Second clade of Gram-positive bacteria encompassed members of the class Actinobacteria under which one major genus Microbacterium was observed. Class wise distribution of the Proteobacterial isolates showed the presence of Alphaproteobacteria, Betaproteobacteria and Gammaproteobacteria. Majority of the clades were affiliated with Gammaproteobacteria, mostly by Pseudomonaceae (43.75%). Other clades of some minor groups such as Enterobacteriaceae, Moraxellaceae, Xanthomonadaceae and Burkholderiaceae were also observed under this major group.
Evolutionary relationships of taxa as inferred using the Neighbor-Joining method. The optimal tree with the sum of branch length = 1.81738518 is shown. The tree is drawn to scale, with branch lengths in the same units as those of the evolutionary distances used to infer the phylogenetic tree. The type strains (T) are marked with black up-pointing triangle. Thermosphaera aggregans DSM 11486 M11TL (NR 044908) was used as outgroup. The numbers at branch nodes indicate bootstrap percentages derived from 1000 replications
A significant difference in microbial diversity was observed in tissues of both cultivated and wild rice. Increases in species diversity are indicated by an increase in Shannon index (H) or reduced evenness (EH). High Shannon diversity index was recorded in roots (H = 2.718 and 1.946) of cultivated and wild rice, followed by stem (H = 2.659 and 1.609). Diversity was least in leaf (H = 2.393 and 1.386) of both cultivated and wild rice. Similarly, species richness calculated with Simpson index (1 − D) showed highest diversity in roots [1 − D(cultivated) = 0.930 and 1 − D(wild) = 0.857]. The overall richness of endophytic bacteria showed highest diversity in root of cultivated rice (Fig. 2; Table 2). The isolates from cultivated rice mostly belonged to ten different genera viz. Acinetobacter, Bacillus, Brevibacillus, Burkholderia, Flavobacterium, Lysenibacillus, Microbacterium, Pseudomonas, Ralstonia and Staphylococcus. A distinction in genera was observed in wild rice where isolates belonged to Bacillus, Brucella, Enterobacter, Fictibacillus, Metabacillus, Microbacterium, Pantoea, Proteus, and Stenotrophomonas (Fig. 3a).
a Pie chart showing diversity of bacterial endophytes isolated from root, stem and leaf of (a) cultivated rice and (b) wild rice. b Distribution of common and unique microflora of cultivar and wild rice variety. Five bacteria (13.9%) were common between both cultivar and wild rice; wile 23 (63.9%) and 8 (22.2%) bacteria were unique to cultivated and wild rice respectively
Unique microfloral distribution study represented in a Venn diagram (Fig. 1) showed 25 (65.8%) and 7 (18.4%) unique species of bacteria in cultivated and wild rice, respectively. Unique microflora of cultivated rice were Acinetobacter soli, A. guillouiae, Bacillus altitudinis, B. aryabhattai, B. paranthracis, B. pseudomycoides, B. siamensis, B. tequilensis, B. timonensis, B. wiedmannii, B. zanthoxyli, Burkholderia territorii, Flavobacterium acidificum, Lysinibacillus fusiformis, Brevibacillus gelatini, Br. brevis, M. hydrothermale, M. kyungheense, M. testaceum, Pseudomonas hunanensis, P. fluorescens, P. plecoglossicida, Ralstonia pseudosolanacearum and Staphylococcus pasteuri. Unique microflora of wild rice was Ochrobactrum tritici, Enterobacter mori, Pantoea dispersa, Fictibacillus aquaticus, Proteus faecis, Metabacillus niabensis and Stenotrophomonas indicatrix. Six bacteria (15.8%) viz. Bacillus cereus, Bacillus paramycoides, Bacillus pumilus, Microbacterium arborescens, M. enclense and M. laevaniformans were common to both cultivar and wild rice.
In case of cultivated rice, members of the genus Bacillus (six species), Microbacterium (two species), Acinetobacter, Pseudomonas, Lysinibacillus, Brevibacillus (one species each) were dominant in roots; Bacillus (eight species), Brevibacillus, Microbacterium, Pseudomonas (two species each), Acinetobacter, Burkholderia, Staphylococcus (one species each) were dominant in the stems and; Bacillus (six species), Microbacterium (three species),: Flavobacterium, Pseudomonas, Ralstonia (one species each) were prevalent in the leaves. Compared to the cultivated rice endosphere, wild rice endosphere carried less bacterial diversity; mostly dominated by Microbacterium (three species), Bacillus, Brucella, Pantoea and Proteus (one species each) in the root endosphere; Microbacterium (two species), Bacillus, Enterobacter, Fictibacillus, Stenotrophomonas (one species each) in the stems and Bacillus, Stenotrophomonas, Metabacillus, Microbacterium (one species each) in the leaves (Fig. 3b).
Screening of isolates for plant growth-promoting properties (PGP)
Phytohormone production
Indole acetic acid (IAA)
In vitro screening for IAA production revealed a substantial variation in the range of IAA (2.33–28.39 μg/ml) production among the 35 positive isolates (Fig. 4a). An isolate from wild rice germplasm, Microbacterium laevaniformans RS0111 produced significantly (p ≤ 0.05) higher amount of IAA (28.39 ± 1.33 µg/ml) when compared to other isolates.
Gibberellic acid (GA) production
Twenty-four isolates showed the ability to produce gibberellic acid (GA) that ranged between 7.94 and 67.23 µg/ml (Fig. 4b). Highest gibberellic acid (67.23 ± 1.67 µg/ml) was produced by Microbacterium laevaniformans RS0111 while the isolate Microbacterium testaceum LP21_R02 produced the least (7.94 ± 0.56 µg/ml).
Mineral solubilisation
Phosphate solubilization
Thirty-five isolates were identified as potential phosphate solubilizers with solubilising efficiency ranging from 6.8 to 81.70 µg/ml (Fig. 5a). Phosphate solubilization activity was significantly (p ≤ 0.05) higher in Bacillus tequilensis RHS01 (81.70 ± 1.3 µg/ml) followed by Brevibacillus brevis RS0105 (60.75 ± 0.24 µg/ml). The bacterium Bacillus tequilensis RHS01 was isolated from cultivated rice germplasm.
Potassium solubilization
Potassium solubilizing efficiencies of the ten positive isolates ranged between 17.67 and 81.33 µg/ml. Microbacterium testaceum MKLS01 (81.33 ± 0.58 µg/ml) and Bacillus paramycoides RHC13 (79.66 ± 1.67 µg/ml) had significantly (p ≤ 0.05) higher ability to solubilize potassium, while Bacillus altitudinis RHS06 had the least potassium solubilizing ability (17.67 ± 0.45 µg/ml).
Zinc solubilization
Bacterial isolates were inoculated in Tris minimal agar medium containing two different insoluble sources of Zn viz., ZnO and ZnS at 0.1% concentration. However, none of the isolates showed solubilization of ZnS. Solubilization efficiency of the positive isolates for ZnO was calculated by measuring the diameter of colony growth and solubilization zone. Zinc solubilizing efficiency of the isolates ranged between 110 and 157.50% (Fig. 5c). Zinc solubilization efficiency was found significantly (p ≤ 0.05) higher in Microbacterium enclense MI03 L05 (157.50%) when compared to Bacillus altitudinis RR01 3D (148.72%) and Staphylococcus pasteuri LP01S02 (109.89%) with least solubilizing efficiency (Fig. 5c).
Siderophore production
For the initial detection of siderophore, bacterial endophytes were grown in modified Fiss minimal medium under low iron conditions. Fourteen bacterial endophytic isolates were found to exhibit siderophore activity. This was further confirmed by CAS shuttle assay in which siderophore production was calculated in terms of percentage of siderophore units (Fig. 6). Siderophore units ranged between 7.06 and 64.80%. Fictibacillus aquaticus LP20 05 produced significantly (p ≤ 0.05) higher siderophore units (64.8%) when compared to Bacillus aryabhattai RLS12 (7.06%).
Efficacy of bio-inoculum on plant growth promotion under greenhouse conditions
Treatments showed varying degree of growth effects as compared to control (T0). Treatment T6 showed significant increase in all the tested parameter compared to control. In T6, higher shoot height (average value of 26.48 cm), number of panicles per plant (average 16.80), total number of seeds per plant (average 463.8 seeds), weight of 100 seeds (average 2.19 gm) and yield per plant (average 10.16 gm) were observed. Length of the flag leaf and dry biomass of the plant were highest in T2 and T6 treatment (Table 3). Pair-wise comparison did not show any significant difference in treatments for number of tillers and number of leaves. All the treatments resulted in significantly higher plant growth when compared to control T0 (Fig. 7).
Discussion
Plant hosts diverse endophytic microbial communities with ability to produce different phytohormones and phytostimulatory compounds. Identification and characterization of such microorganisms from various ecological niches with diverse agro-climatic condition have potential for development of bioinoculum targeted for sustainable agricultural practices (Afzal et al. 2019). Endophytic microorganisms are taxonomically diverse and produces myriad of molecules which help plant host to adapt and survive in biotic and abiotic stresses. In this study, biochemical characterization of the isolated bacteria reflected the dominance of Gram-positive endophytes over the Gram-negative members. Endophytic bacterial diversity was measured in terms of Shannon (H) and Simpson (1 − D) diversity indices. Roots being the primary and dynamic site of plant–microbe interaction, high indices were noted for roots of both cultivated (H = 2.718, 1 − D = 0.930) and wild (H = 1.946, 1 − D = 0.857) rice.
Firmicutes (57.1%) were the major colonizer of rice tissues particularly from the genus Bacillus. Several studies have already demonstrated Bacillus to be an efficient and rapid plant-tissue colonizer with proven biocontrol and PGP activities (Gond et al. 2015; Zhao et al. 2015; Tamošiūnė et al. 2018). Endophytic association of Bacillus was reported from several plants including Coffea arabica L., sunflower, cotton, potato, strawberry, Panaxnoto ginseng and citrus (Araújo et al. 2001; Sessitsch et al. 2004; Vega et al. 2005; Forchetti et al. 2007; Dias et al. 2009; Ma et al. 2013). Metabolic versatility of Bacillus in production of a multilayered cell wall structure, formation of stress-resistant endospores, secretion of antibiotics, signal molecules and extracellular enzymes enables them to survive in diverse ecological systems (Lyngwi et al. 2016). Following the Firmicutes, Actinobacteria (20%) and Proteobacteria (22.9%) were the two dominant phyla identified. Phylum Actinobacteria was mostly represented by the family Microbacteriaceae with Microbacterium as the identified genera. Association of Microbacterium as endophyte has been previously reported from maize, rice and wheat (Elbeltagy et al. 2001; Conn and Franco 2004; Rijavec et al. 2007). In Proteobacteria, Pseudomonas was the major genus which accounted for 31.25% of the total number of isolates. Genus Pseudomonas is a widely distributed plant-associated bacterium with reported plant growth-promoting activity in alfalfa (Gagné et al. 1987), clover (Sturz et al. 1997), potato (Reiter et al. 2002), and pea (Elvira-Recuenco and van Vuurde 2000). Some minor groups such as Enterobacteriaceae, Brucellaceae, Erwiniaceae, Morganellaceae, Lysobacteraceae, Moraxellaceae were also observed from Proteobacterial phylum.
Molecular characterization of the isolates using 16S rRNA gene showed that Bacillus, Microbacterium, Brevibacillus, Lysenibacillus and Staphylococcus were the top-five genera associated with cultivated rice endosphere, while Bacillus, Stenotrophomonas, Microbacterium, Brucella and Proteus were the top-five bacterial genera associated with wild rice endosphere. Bacterial species such as Bacillus cereus, B. paramycoides, B. pumilus, Microbacterium arborescens, M. enclense and M. laevaniformans were common to both cultivated and wild rice. Wild rice mainly grows in the waterlogged marshy soils where abiotic stress is common, while cultivated varieties are traditionally grown supplemented with all required nutrients. Oryza rufipogon Griff. sparsely distributed in the tropics and subtropics of Asia is regarded as the progenitor of cultivated rice O. sativa L. (Vaughan 1994). Cultivated rice, i.e. Oryza sativa has lost many desirable traits including disease and drought resistance in its course of domestication from O. rufipogon. This process of domestication is still evident from the occurrence of many natural hybrids between O. rufipogon and O. sativa reported from several locations (Suh et al. 1997; Song et al. 2002, 2005). During the process of domestication of wild rice, the associated microorganisms such as endophytes, AMF, rhizobacteria, etc. also have undergone natural selection in the light of evolving host and changing environmental factors (Tian et al. 2017). In fact, these microorganisms play a key role in plants’ defense mechanism through direct plant–microbe interaction, which is more prominent in the wild species (Kuklinsky-Sobral et al. 2004; Hardoim et al. 2008). Destruction of natural wild rice habitat through anthropogenic activities, changes in climate and hydrology, overgrazing, pollution, and population pressure from popular Oryza sativa, have led this species to the edge of extinction (Gao and Zhang 2005). We assume that such competition and selection pressure have fueled marginalization and adaptation in O. rufipogon through the selective acquisition of host-specific beneficial endophytes. In this study, it was found that endophytic bacteria viz., Stenotrophomonas indicatrix, Proteus faecis, Metabacillus niabensis, Fictibacillus aquaticus, Pantoea dispersa, Ochrobactrum tritici, Enterobacter mori were unique to O. rufipogon. Most of these bacteria have been either reported to promote plant growth or protect the plant under various biotic and abiotic stress factors. For example, most of the Stenotrophomonas members are known as opportunistic bacteria frequently encountered both in the rhizosphere and the endosphere of plants (Hayward et al. 2010). These bacteria have been demonstrated to enhance biomass production in various crops such as canola (De Freitas et al. 1997), potato (Sturz et al. 2001), sorghum (IDRIS et al. 2009), poplar (van der Lelie et al. 2009) and corn (Mehnaz et al. 2010). Stenotrophomonas can transmit and propagate via seeds and can spill out of the host to nearby rhizosphere and surrounding soils (Hardoim et al. 2012). Enterobacter mori strain HZ21 isolated from root nodules of black locust (Robinia pseudoacacia) has been reported to show resistance to multiple heavy metals such as Cd, Zn, Pb and Cu (Fan et al. 2018). Similarly, endophytic Pantoea dispersa has been reported to carry biocontrol properties. Four different strains of the same bacterium strongly inhibited the mycelium growth and spore germination of phytopathogenic Ceratocytis fimbriata (causal agent of black rot) in a susceptible sweet potato cultivar. Fluorescence microscopy confirmed the colonization of the strains in the intercellular spaces of the vascular tissues (Jiang et al. 2019). From this discussion, it is clear that wild rice plant can manipulate soil biota community and acquire beneficial microbes to gain certain advantages under compromised habitat conditions.
Bacteria such as Acinetobacter soli, A. guillouiae, Bacillus altitudinis, B. aryabhattai, B. cereus, B. paranthracis, B. paramycoides, B. pseudomycoides, B. pumilus, B. siamensis, B. tequilensis, B. timonensis, B. wiedmannii, B. zanthoxyli, Brevibacillus gelatini, Burkholderia territorii, Flavobacterium acidificum, Lysinibacillus fusiformis, Microbacterium kyungheense, Pseudomonas hunanensis, P. fluorescens, P. plecoglossicida, Microbacterium arborescens, M. enclense, M. hydrothermale, M. kyungheense, M. laevaniformans, M. testaceum, Ralstonia pseudosolanacearum and Staphylococcus pasteuri were found unique to cultivated rice. It is noteworthy that most of the species belonged to the genus Bacillus which is a rapid tissue coloniser with potential disease control properties (Shafi et al. 2017). Endophytic colonization of Burkholderia in Oryza sativa plants is already reported. Colonization by Burkholderia kururiensis confers beneficial effects on the growth and seed production of rice plants, possibly associated to differential auxin balance which enhances the rice plant development (Mattos et al. 2008). Additional studies also have demonstrated that bacterial isolates with IAA production ability can efficiently colonize rice endosphere and exhibit beneficial effects on the growth of rice plants, possibly through the modulation of phytohormones (Etesami et al. 2014). There are several reports on Bacillus, Pseudomonas, Burkholderia, Staphylococcus, Acinetobacter as seed endophytes. Inside seeds, these endophytic bacterial strains mediate various positive interactions such as nutrient acquisition, synthesis of growth regulators, along with biotic and abiotic stress management (Kumar et al. 2020). Endophytes are often studied as a collective group where plant-tissue specific colonization patterns are rarely considered. Lack of compartmental colonization study often fails in identifying actual role of endophytes in plant growth promotion. Tissue specific annotation of endophytic species showed distinct differentiation in colonizing pattern across the different parts of plants. Difference in H- and 1 − D index also asserted that there was a variation in the distribution of endophytic bacteria in different plant tissue. For example, in case of cultivated rice, major root endophytes were Acinetobacter guillourie, Bacillus altitidinus, B. aryabhattai, B. mycoides and Lysenibacillus fusiformis, while in wild rice, Bacillus paramycoides, Ochrobactrum tritici, Microbacterium arborescens, Pantoea dispersa and Proteus faecis were the dominant root endophytes. In cultivated rice, bacterial species such as Acinetobacter soli, B. cereus, B. siamensis, B. wiedmannii, Brevibacillus gelatini, Br. brevis, Burkholderia territorii, M. laevaniformans, Pseudomonas hunanensis, Staphylococcus pasteuri, etc. were prevalent in the stem, while species such as B. pumilus, B. zanthoxyli, Flavobacterium acidificum, M. enclense, M. hydrothermale, Pseudomonas fluorescens, Ralstonia pseudosolanacearum were present in the leaves. Diversity of Acinetobacter soli, Bacillus altitudinis, B. aryabhattai, B. paranthracis, B. siamensis, B. tequilensis, B. wiedmannii, Brevibacillus gelatini, Br. brevis, Burkholderia territorii, M. kyungheense, Pseudomonas hunanensis and Staphylococcus pasteuri was mostly restricted to stems in cultivated rice, while Enterobacter mori, Fictibacillus aquaticus, Microbacterium enclense and Stenotrophomonas indicatrix were dominant in the stem of wild rice. Compared to the leaf-endosphere of cultivated rice, bacterial diversity in the leaves of wild rice endosphere was less diverse and mainly inhabited by bacterial species such as Bacillus pumilus, Metabacillus niabensis, Microbacterium arborescens and Stenotrophomonas indicatrix. Generally, the plant roots harbor more bacterial communities than other plant parts due to the primary site of interaction between plants and rhizosphere. Most of the endophytes enter into the plant tissues through root and only a few can penetrate the xylem vessels through the casparian strip. The microbes which enter into the xylem vessels slowly move towards the apical parts of the plant and hence the relative abundance of microorganisms decreases from root to stem and leaf (Gasser et al. 2011). Microbial population and their diversity in the rhizosphere is a major or key factor contributor for density and diversity of endophytes in host plant (Hallmann and Berg 2006). Some rhizoplane-colonizing bacteria can penetrate plant roots, and some strains may move to stem and leaves, with a lower bacterial density in comparison to root-colonizing populations (Compant et al. 2010). Earlier, higher endophytic bacteria density in rice roots compared to other parts of the plant has been reported (Prakamhang et al. 2009).
In parallel to studies revolving around endophytic microflora diversity and ecological niche distribution, it is imperative that these identified bacteria should be prospected towards the development of efficient bioinoculants with potential agricultural implications. Therefore, further studies were carried out to characterize the endophytic bacterial isolates for their promising plant-growth-promoting traits. Endophytes can directly or indirectly influence growth and development of plants without causing any pathogenic effect. Mutualistic interaction is facilitated by number of metabolites linked with mechanisms likemobilizations and uptake of nutrients and production or co-regulation of phytohormone synthesis pathways. Phytohormone production by endophytes is perhaps the most-studied mechanism of plant growth promotion (Long et al. 2008). Indole-3-acetic acid (IAA) is the most common auxin found in plant (Barazani and Friedman 1999), which regulates various aspects of plant growth and development including cell division and elongation, tissue differentiation, apical dominance, and responses to light, gravity and pathogens (Aloni et al. 2006). Our study revealed Microbacterium laevaniformans RS0111, an isolate from wild rice germplasm as a significant producer of IAA (28.39 ± 1.33 µg/ml) followed by Microbacterium testaceum MKLS01 (24.25 ± 0.90 µg/ml). Members of the Microbacterium genera are already known to produce high levels of free IAA (Gilbert et al. 2018; Dhungana and Itoh 2019). Gibberellic acid (GA), a major phytohormone is responsible for seed germination and mobilization of nutrients for the growth of a new cell. Microbacterium laevaniformans RS01 11 RS0111 produced maximum GA (67.23 ± 1.67 µg/ml) followed by Bacillus tequilensis RHS 01 (57.63 ± 1.57) in this study. Synthesis of GA was reported from several bacterial species including Acinetobacter, Azospirillum brasilense, Agrobacterium, Arthrobacter, A. lipoferum, Azotobacter, Bacillus, Bradyrhizobium japonicum, Flavobacterium, Micrococcus, Clostridium, Pseudomonas, Rhizobium, Xanthomonas (Gutierrez-Manero et al. 2001), Pseudomonas and Bacillus(Maheswari and Komalavalli 2013). However, to the best of our knowledge, this is the first report on rice endophytic Microbacterium laevaniformans with both IAA and GA secretion ability. Plant growth and yield essentially depend on the bioavailability of minerals which they directly or indirectly acquire from the soil. In soils, most of the phosphorus exists in the form of insoluble mineral complexes which plants cannot directly absorb (Rengel and Marschner 2005). Phosphate-solubilising bacteria (PSB) are able to solubilise bound/organic phosphorous to inorganic orthophosphates by secretion of organic acids or producing enzymes such as phosphatases or C-P lyases (Kim et al. 1998; Chung et al. 2005). This study revealed Bacillus tequilensis RHS 01 as a potent phosphate solubilizer (81.70 ± 1.3 µg/m) followed by Brevibacillus brevis RS01 05 (60.75 ± 0.24 µg/ml). These endophytic bacterial isolates were able to solubilize organic or inorganic form of phosphate suggesting that they could play a role in resource mobilization in nutrient-poor habitat. Previous reports suggest the efficiency of endophytic bacteria such as Bacillus subtilis and B. megaterium isolated from strawberry in solubilization of tricalcium phosphate (Dias et al. 2009). Potassium is a major nutrient for plant growth and development, which provides an ionic environment for metabolic process in the cytosol and as a growth regulator. Microbacterium testaceum MKLS01 (81.33 ± 0.58 µg/ml) and Bacillus paramycoides RHC 13 (79.66 ± 1.67 µg/ml) solubilized the highest amount of potassium in the study. Several studies reported Bacillus and Microbacterium as potential potassium solubilizers (Diep 2013; Nair and Padmavathy 2014; Zhang and Kong 2014). Zinc is an essential mineral for chlorophyll synthesis. Zinc solubilizing microorganisms have the ability to dissolve the zinc phosphate, zinc oxide and zinc carbonate in considerable quantity (Saravanan et al. 2007). In the present study, Microbacterium enclense MI03L05 and Bacillus altitudinis RR013D showed significant zinc solubilization efficiency (157.50% and 148.64%, respectively). Bacterial genera viz. Acinetobacter, Bacillus, Gluconacetobacter, Pseudomonas, Thiobacillus thioxidans, Thiobacillus ferroxidans, and facultative thermophiliciron oxidizers have also been reported as zinc solubilizers (Saravanan et al. 2007). Endophytic Bacillus and Pseudomonas species isolated from soybean were also reported to solubilize zinc (Ramesh et al. 2014). Production of siderophore for iron chelation is an important trait in endophytic bacteria. Despite being the most available element in the earth crust, the bioavailability of iron is very limited due to the low solubility of Fe3+ ions. Siderophores, are the strongest binding agent of Fe3+. A number of plant species can directly absorb the bacterial Fe3+ siderophore complexes (Beneduzi et al. 2012). Fictibacillus aquaticus LP20 05 (64.8%) was found to exhibit highest siderophore production activity, followed by Lysenibacillus fusiformis LP01R08 (55.05%). Earlier, rhizospheric bacteria Bacillus barbaricus and Pseudomonas fluorescens have been reported to exhibit high (21% and 76%, respectively) siderophore production (Gupta and Gopal 2008).
Based on promising in-vitro phytostimulant activities, three candidate endophytes viz. Microbacterium laevaniformans RS0111, Bacillus tequilensis RHS01 and Microbacterium testaceum MKLS01 were selected for pot-culture validation experiment. These bacterial isolates were proportionately mixed to form a bio-inoculant and compared with different combinations of chemical fertilizer (NPK) and vermicompost. The pot-culture experiment revealed T6 treatment (soil + ½ NPK + ½ vermicompost + ½ bioinoculum) as an effective combination for shoot heights, number of tillers, number of panicles, the total number of seeds per plant, weight of 100 grains and yield per plant. The T6 treatment resulted in significantly (p ≤ 0.05) higher increase on growth and yield parameters when compared to control T0 and T1 (commercial NPK). Initial growth in bioinoculum treatment was slow and delayed. The delay in acclimatization and colonization of the microorganisms in soil and rhizosphere may initially take time to show the benefit, however, once established the PGPB enhanced plant growth and yield. Endophytic PGPB are good candidates to be used as inoculant as they can colonize roots and create a favorable environment for development and yield (Bacon and Hinton 2007).
The mechanisms by which bacteria can influence plant growth differ by genus and species. There is no single mechanism for promoting plant growth (Souza et al. 2015). Hence, mechanisms that stimulated plant growth could be explained by combined effects of all the PGPR properties like phytohormone (IAA and GA) production and mineral (phosphate, potassium and zinc) solubilisation of each isolate present in the bio-inoculum. Microbacterium laevaniformans RS0111 had phytohormone biosynthesis capacity which stimulated the process of plant growth. The secretion of IAA might have aided in improving root development while GA in promoting shoot growth. Bacillus tequilensis RHS 01 and Microbacterium testaceum MKLS01 were efficient phosphate and potassium solubilizers, respectively. Bacillus tequilensis RHS 01 and Microbacterium testaceum MKLS01 were also characterized as good zinc solubilizers, which might have helped the process of growth enhancement. Earlier greenhouse and pot culture studies with the endophytic rhizobial inoculum indicated the significant increase in N, P and K uptake in rice plants and led to increased biomass and yield of rice plants (Biswas et al. 2000).
Conclusion
The focus of this study was to generate baseline information primarily on the tissue-specific colonization and distribution patterns of culturable bacterial endophytes in wild and cultivated rice germplasm of Assam, India. The growth and resilience of wild rice varieties growing on marginal and waterlogged sites are largely influenced by the endophytic microbial population. Several bacterial endophytes harboured by cultivated and their wild counterparts have drawn considerable scientific attention for their synergistic plant growth-promoting activities. Therefore, secondary focus of this study was to prospect such endophytes with promising PGP activities from these rice germplasm. Culture-dependent approaches revealed 255 potential bacterial endophytes from different plant parts (leaf, stem and root) of both cultivated and wild rice plants. Of these 255 isolates, 70 morphologically distinct entries were identified through phenotypical, biochemical and molecular characterization. Information on the 16S rRNA gene sequencing products can be retrieved from NCBI public database (Accession numbers: KF953537-KF953539, KF957732-KF957737, KM350264-KM350269, KM977824-KM977837, KP419696-KP419697, KT380663-KT380685, KT427902-KT427910, KT427913-KT427917, KX375411-KX375413, and MF503997-MF503998). It is well known that the rhizospheric region is the primary site of interaction between the endophytes and the plant system. In this line, we too observed high Shannon diversity indices at the root endosphere, with firmicutes as the primary root colonizers. Members of the genus Bacillus, Brevibacillus, Lysenibacillus etc. were most abundant in cultivated rice, while Bacillus, Stenotrophomonas, Microbacterium were mostly dominant in the wild rice endosphere.
Furthermore, three most promising bacterial endophytes viz., Microbacterium laevaniformans RS0111 isolated from wild rice endosphere, and Bacillus tequilensis RHS01 and Microbacterium testaceum MKLS01 isolated from cultivated rice endosphere displayed PGP traits such as production of phytohormone (IAA and GA) production and mineral (phosphate, potassium and zinc) solubilisation which were further validated in rice plant through pot-culture experiment. A combination of this bioinoculum with half recommended doses of vermicompost and NPK was found to be most effective for plant and panicle growth along with increased yield. These results suggest that this bioinoculant can help reduce the excessive dependence on chemical fertilizers (at least to half) in agriculture.
While this study was partially successful in inferring the differential bacterial diversity associated with the wild and cultivated rice species, many questions still remain. These include the temporal and spatial distributions of endophytes in these two plant systems; signalling molecules, mechanisms and pathway essential for colonization in both the systems; and the exact role of endophytic microbiome in these germplasm under different biotic and abiotic stress environments. Further studies on these aspects may shed more lights on the pattern and process of bacterial endophyte colonization.
Availability of data and materials
The 16S rRNA gene information is publically available in the NCBI database.
References
Afzal I, Shinwari ZK, Sikandar S, Shahzad S (2019) Plant beneficial endophytic bacteria: mechanisms, diversity, host range and genetic determinants. Microbiol Res 221:36–49. https://doi.org/10.1016/j.micres.2019.02.001
Aloni R, Aloni E, Langhans M, Ullrich CI (2006) Role of auxin in regulating Arabidopsis flower development. Planta 223:315–328. https://doi.org/10.1007/s00425-005-0088-9
Altschul SF, Gish W, Miller W et al (1990) Basic local alignment search tool. J Mol Biol 215:403–410. https://doi.org/10.1016/S0022-2836(05)80360-2
Araújo WL, Maccheroni W Jr, Aguilar-Vildoso CI et al (2001) Variability and interactions between endophytic bacteria and fungi isolated from leaf tissues of citrus rootstocks. Can J Microbiol 47:229–236. https://doi.org/10.1139/w00-146
Arnold AE (2007) Understanding the diversity of foliar endophytic fungi: progress, challenges, and frontiers. Fungal Biol Rev 21:51–66. https://doi.org/10.1016/j.fbr.2007.05.003
Bacon CW, Hinton DM (2007) Bacterial endophytes: the endophytic niche, its occupants, and its utility. Plant-associated bacteria. Springer, Netherlands, Dordrecht, pp 155–194
Barazani O, Friedman J (1999) Is IAA the major root growth factor secreted from plant-growth-mediating bacteria? J Chem Ecol 25:2397–2406. https://doi.org/10.1023/A:1020890311499
Beneduzi A, Ambrosini A, Passaglia LMP (2012) Plant growth-promoting rhizobacteria (PGPR): their potential as antagonists and biocontrol agents. Genet Mol Biol 35:1044–1051
Bergey D (1974) Bergey’s manual of determinative bacteriology, 8th edn. Williams & Wilkins Co., Baltimore
Biswas JC, Ladha JK, Dazzo FB (2000) Rhizobia inoculation improves nutrient uptake and growth of lowland rice. Soil Sci Soc Am J 64:1644–1650. https://doi.org/10.2136/sssaj2000.6451644x
Choudhury B, Khan ML, Dayanandan S (2013) Genetic structure and diversity of indigenous rice (Oryza sativa) varieties in the Eastern Himalayan region of Northeast India. Springerplus 2:228. https://doi.org/10.1186/2193-1801-2-228
Chung H, Park M, Madhaiyan M et al (2005) Isolation and characterization of phosphate solubilizing bacteria from the rhizosphere of crop plants of Korea. Soil Biol Biochem 37:1970–1974. https://doi.org/10.1016/j.soilbio.2005.02.025
Compant S, Clément C, Sessitsch A (2010) Plant growth-promoting bacteria in the rhizo- and endosphere of plants: their role, colonization, mechanisms involved and prospects for utilization. Soil Biol Biochem 42:669–678
Conn VM, Franco CMM (2004) Analysis of the endophytic actinobacterial population in the roots of wheat (Triticum aestivum L.) by terminal restriction fragment length polymorphism and sequencing of 16S rRNA clones. Appl Environ Microbiol 70:1787–1794. https://doi.org/10.1128/AEM.70.3.1787-1794.2004
Das S, Barooah M, Thakur N (2019) Endophytic virome. bioRxiv 602144. https://doi.org/10.1101/602144
De Freitas JR, Banerjee MR, Germida JJ (1997) Phosphate-solubilizing rhizobacteria enhance the growth and yield but not phosphorus uptake of canola (Brassica napus L.). Biol Fertil Soils 24:358–364. https://doi.org/10.1007/s003740050258
de Souza R, Ambrosini A, Passaglia LMP (2015) Plant growth-promoting bacteria as inoculants in agricultural soils. Genet Mol Biol 38:401–419. https://doi.org/10.1590/S1415-475738420150053
Dhungana SA, Itoh K (2019) Effects of co-inoculation of indole-3-aceticacid-producing and -degrading bacterial endophyteson plant growth. Horticulturae 5:1–9
Dias ACF, Costa FEC, Andreote FD et al (2009) Isolation of micropropagated strawberry endophytic bacteria and assessment of their potential for plant growth promotion. World J Microbiol Biotechnol 25:189–195. https://doi.org/10.1007/s11274-008-9878-0
Diep CN (2013) Phosphate and potassium solubilizing bacteria from weathered materials of denatured rock mountain, Ha Tien, Kien Giang Province, Vietnam. Am J Life Sci 1:88. https://doi.org/10.11648/j.ajls.20130103.12
Elbeltagy A, Nishioka K, Sato T et al (2001) Endophytic colonization and in planta nitrogen fixation by a Herbaspirillum sp. isolated from wild rice species. Appl Environ Microbiol 67:5285–5293. https://doi.org/10.1128/AEM.67.11.5285-5293.2001
Elvira-Recuenco M, van Vuurde JW (2000) Natural incidence of endophytic bacteria in pea cultivars under field conditions. Can J Microbiol 46:1036–1041
Etesami H, Mirseyed Hosseini H, Alikhani HA (2014) In planta selection of plant growth promoting endophytic bacteria for rice (Oryza sativa L.). J Soil Sci Plant Nutr 14:491–503. https://doi.org/10.4067/S0718-95162014005000039
Fan M, Liu Z, Nan L et al (2018) Isolation, characterization, and selection of heavy metal-resistant and plant growth-promoting endophytic bacteria from root nodules of Robinia pseudoacacia in a Pb/Zn mining area. Microbiol Res 217:51–59. https://doi.org/10.1016/j.micres.2018.09.002
Forchetti G, Masciarelli O, Alemano S et al (2007) Endophytic bacteria in sunflower (Helianthus annuus L.): isolation, characterization, and production of jasmonates and abscisic acid in culture medium. Appl Microbiol Biotechnol 76:1145–1152. https://doi.org/10.1007/s00253-007-1077-7
Fukui R (1994) Interaction between strains of pseudomonads in sugar beet spermospheres and their relationship to pericarp colonization by pythium ultimum in soil. Phytopathology 84:1322. https://doi.org/10.1094/Phyto-84-1322
Gagné S, Richard C, Rousseau H, Antoun H (1987) Xylem-residing bacteria in alfalfa roots. Can J Microbiol 33:996–1000. https://doi.org/10.1139/m87-175
Gao LZ, Zhang CH (2005) Comparisons of microsatellite variability and population genetic structure of two endangered wild rice species, Oryza rufipogon and O. officinalis, and their conservation implications. Biodivers Conserv 14:1663–1679. https://doi.org/10.1007/s10531-004-0537-y
Gasser I, Cardinale M, Müller H et al (2011) Analysis of the endophytic lifestyle and plant growth promotion of Burkholderia terricola ZR2-12. Plant Soil 347:125–136. https://doi.org/10.1007/s11104-011-0833-8
Gilbert S, Xu J, Acosta K et al (2018) Bacterial production of indole related compounds reveals their role in association between duckweeds and endophytes. Front Chem 6:265. https://doi.org/10.3389/fchem.2018.00265
Glick BR (2014) Bacteria with ACC deaminase can promote plant growth and help to feed the world. Microbiol Res 169:30–39. https://doi.org/10.1016/j.micres.2013.09.009
Gond SK, Bergen MS, Torres MS, White JF Jr (2015) Endophytic Bacillus spp. produce antifungal lipopeptides and induce host defence gene expression in maize. Microbiol Res 172:79–87. https://doi.org/10.1016/j.micres.2014.11.004
Gupta A, Gopal M (2008) Siderophore production by plant growth promoting rhizobacteria
Gutierrez-Manero FJ, Ramos-Solano B, Probanza AN et al (2001) The plant-growth-promoting rhizobacteria Bacillus pumilus and Bacillus licheniformis produce high amounts of physiologically active gibberellins. Physiol Plant 111:206–211. https://doi.org/10.1034/j.1399-3054.2001.1110211.x
Hallmann J, Berg G (2006) Spectrum and population dynamics of bacterial root endophytes. Microbial root endophytes. Springer, Berlin , pp 15–31
Hammer DAT, Ryan PD, Hammer Ø, Harper DAT (2001) Past: paleontological statistics software package for education and data analysis
Hardoim PR, van Overbeek LS, van Elsas JD (2008) Properties of bacterial endophytes and their proposed role in plant growth. Trends Microbiol 16:463–471. https://doi.org/10.1016/j.tim.2008.07.008
Hardoim PR, Hardoim CCP, van Overbeek LS, van Elsas JD (2012) Dynamics of seed-borne rice endophytes on early plant growth stages. PLoS One 7. https://doi.org/10.1371/journal.pone.0030438
Hayward AC, Fegan N, Fegan M, Stirling GR (2010) Stenotrophomonas and lysobacter: ubiquitous plant-associated gamma-proteobacteria of developing significance in applied microbiology. J Appl Microbiol 108:756–770
Hiruma K, Gerlach N, Sacristán S et al (2016) Root endophyte Colletotrichum tofieldiae confers plant fitness benefits that are phosphate status dependent. Cell 165:464–474. https://doi.org/10.1016/j.cell.2016.02.028
Hu X, Chen J, Guo J (2006) Two phosphate- and potassium-solubilizing bacteria isolated from Tianmu Mountain, Zhejiang, China. World J Microbiol Biotechnol 22:983–990. https://doi.org/10.1007/s11274-006-9144-2
Idris A, Labuschagne N, Korsten L (2009) Efficacy of rhizobacteria for growth promotion in sorghum under greenhouse conditions and selected modes of action studies. J Agric Sci 147:17–30. https://doi.org/10.1017/S0021859608008174
Jackson ML (1973) Soil chemical analysis. Prentice Hall of India (Pvt.) Ltd, New Delhi
Jiang L, Jeong JC, Lee J-S et al (2019) Potential of Pantoea dispersa as an effective biocontrol agent for black rot in sweet potato. Sci Rep 9:16354. https://doi.org/10.1038/s41598-019-52804-3
Kandel S, Joubert P, Doty S (2017) Bacterial endophyte colonization and distribution within plants. Microorganisms 5:77. https://doi.org/10.3390/microorganisms5040077
Kim KY, Jordan D, McDonald G (1998) Enterobacter agglomerans, phosphate solubilizing bacteria, and microbial activity in soil: effect of carbon sources. Soil Biol Biochem 30:995–1003. https://doi.org/10.1016/S0038-0717(98)00007-8
Kimura M (1980) A simple method for estimating evolutionary rates of base substitutions through comparative studies of nucleotide sequences. J Mol Evol 16:111–120. https://doi.org/10.1007/BF01731581
Klironomos JN (2002) Feedback with soil biota contributes to plant rarity and invasiveness in communities. Nature 417:67–70. https://doi.org/10.1038/417067a
Kuklinsky-Sobral J, Araujo WL, Mendes R et al (2004) Isolation and characterization of soybean-associated bacteria and their potential for plant growth promotion. Environ Microbiol 6:1244–1251. https://doi.org/10.1111/j.1462-2920.2004.00658.x
Kumar A, Singh S, Gaurav AK et al (2020) Plant growth-promoting bacteria: biological tools for the mitigation of salinity stress in plants. Front Microbiol 11:1216
Long HH, Schmidt DD, Baldwin IT (2008) Native bacterial endophytes promote host growth in a species-specific manner; phytohormone manipulations do not result in common growth responses. PLoS ONE 3:e2702. https://doi.org/10.1371/journal.pone.0002702
Lyngwi NA, Nongkhlaw M, Kalita D, Joshi SR (2016) Bioprospecting of plant growth promoting bacilli and related genera prevalent in soils of pristine sacred groves: biochemical and molecular approach. PLoS ONE 11:e0152951. https://doi.org/10.1371/journal.pone.0152951
Ma L, Cao YH, Cheng MH et al (2013) Phylogenetic diversity of bacterial endophytes of Panax notoginseng with antagonistic characteristics towards pathogens of root-rot disease complex. Antonie Van Leeuwenhoek 103:299–312. https://doi.org/10.1007/s10482-012-9810-3
Maheswari NU, Komalavalli R (2013) Diversity of soil fungi from Thiruvarur District, Tamil Nadu, India. undefined
Mattos KA, Pádua VLM, Romeiro A et al (2008) Endophytic colonization of rice (Oryza sativa L.) by the diazotrophic bacterium Burkholderia kururiensis and its ability to enhance plant growth. An Acad Bras Cienc 80:477–493. https://doi.org/10.1590/s0001-37652008000300009
Mehnaz S, Kowalik T, Reynolds B, Lazarovits G (2010) Growth promoting effects of corn (Zea mays) bacterial isolates under greenhouse and field conditions. Soil Biol Biochem 42:1848–1856. https://doi.org/10.1016/j.soilbio.2010.07.003
Mei C, Flinn B (2010) The use of beneficial microbial endophytes for plant biomass and stress tolerance improvement. Recent Pat Biotechnol 4:81–95. https://doi.org/10.2174/187220810790069523
Nair DN, Padmavathy S (2014) Impact of endophytic microorganisms on plants, environment and humans. Sci World J 2014:1–11. https://doi.org/10.1155/2014/250693
Paleg LG, Coombe BG (1967) Physiological effects of gibberellic acid. IX. Recovery of gibberellic acid following incubation with endosperm
Patten CL, Glick BR (2002) Role of Pseudomonas putida indoleacetic acid in development of the host plant root system. Appl Environ Microbiol 68:3795–3801. https://doi.org/10.1128/AEM.68.8.3795-3801.2002
Payne SM (1994) Detection, isolation, and characterization of siderophores. Methods Enzymol 235:329–44. https://doi.org/10.1016/0076-6879(94)35151-1
Pillay VK, Nowak J (1997) Inoculum density, temperature, and genotype effects on in vitro growth promotion and epiphytic and endophytic colonization of tomato (Lycopersicon esculentum L.) seedlings inoculated with a pseudomonad bacterium. Can J Microbiol 43:354–361. https://doi.org/10.1139/m97-049
Prakamhang J, Minamisawa K, Teamtaisong K et al (2009) The communities of endophytic diazotrophic bacteria in cultivated rice (Oryza sativa L.). Appl Soil Ecol 42:141–149. https://doi.org/10.1016/j.apsoil.2009.02.008
Ramesh A, Sharma SK, Sharma MP et al (2014) Inoculation of zinc solubilizing Bacillus aryabhattai strains for improved growth, mobilization and biofortification of zinc in soybean and wheat cultivated in Vertisols of central India. Appl Soil Ecol 73:87–96. https://doi.org/10.1016/j.apsoil.2013.08.009
Reiter B, Pfeifer U, Schwab H, Sessitsch A (2002) Response of endophytic bacterial communities in potato plants to infection with Erwinia carotovora subsp. atroseptica. Appl Environ Microbiol 68:2261–2268. https://doi.org/10.1128/AEM.68.5.2261-2268.2002
Rengel Z, Marschner P (2005) Nutrient availability and management in the rhizosphere: exploiting genotypic differences. New Phytol 168:305–312. https://doi.org/10.1111/j.1469-8137.2005.01558.x
Rijavec T, Lapanje A, Dermastia M, Rupnik M (2007) Isolation of bacterial endophytes from germinated maize kernels. Can J Microbiol 53:802–808. https://doi.org/10.1139/W07-048
Rosenblueth M, Martínez-Romero E (2006) Bacterial endophytes and their interactions with hosts. Mol Plant-Microbe Interact 19:827–837. https://doi.org/10.1094/MPMI-19-0827
Saravanan VS, Kalaiarasan P, Madhaiyan M, Thangaraju M (2007) Solubilization of insoluble zinc compounds by gluconacetobacter diazotrophicus and the detrimental action of zinc ion (Zn2+) and zinc chelates on root knot nematode Meloidogyne incognita. Lett Appl Microbiol 44:235–241. https://doi.org/10.1111/j.1472-765X.2006.02079.x
Schwyn B, Neilands JB (1987) Universal chemical assay for the detection and determination of siderophores. Anal Biochem 160:47–56. https://doi.org/10.1016/0003-2697(87)90612-9
Sessitsch A, Reiter B, Berg G (2004) Endophytic bacterial communities of field-grown potato plants and their plant-growth-promoting and antagonistic abilities. Can J Microbiol 50:239–249. https://doi.org/10.1139/w03-118
Shafi J, Tian H, Ji M (2017) Bacillus species as versatile weapons for plant pathogens: a review. Biotechnol Biotechnol Equip 31:446–459. https://doi.org/10.1080/13102818.2017.1286950
Shahzad R, Khan AL, Bilal S, et al (2018) What is there in seeds? Vertically transmitted endophytic resources for sustainable improvement in plant growth. Front Plant Sci 9. https://doi.org/10.3389/fpls.2018.00024
Song Z, Lu B, Zhu Y, Chen J (2002) Pollen competition between cultivated and wild rice species (Oryza sativa and O. rufipogon). New Phytol 153:289–296
Song Z, Li B, Chen J, Lu B-R (2005) Genetic diversity and conservation of common wild rice (Oryza rufipogon) in China. Plant Species Biol 20:83–92. https://doi.org/10.1111/j.1442-1984.2005.00128.x
Strobel G, Daisy B, Castillo U, Harper J (2004) Natural products from endophytic microorganisms. J Nat Prod 67:257–268. https://doi.org/10.1021/np030397v
Sturz AV, Christie BR, Matheson BG, Nowak J (1997) Biodiversity of endophytic bacteria which colonize red clover nodules, roots, stems and foliage and their influence on host growth. Biol Fertil Soils 25:13–19. https://doi.org/10.1007/s003740050273
Sturz AV, Matheson BG, Arsenault W et al (2001) Weeds as a source of plant growth promoting rhizobacteria in agricultural soils. Can J Microbiol 47:1013–1024. https://doi.org/10.1139/w01-110
Suh HS, Sato YI, Morishima H (1997) Genetic characterization of weedy rice (Oryza sativa L.) based on morpho-physiology, isozymes and RAPD markers. Theor Appl Genet 94:316–321. https://doi.org/10.1007/s001220050417
Sun Z-K, He W-M (2010) Evidence for enhanced mutualism hypothesis: Solidago canadensis plants from regular soils perform better. PLoS ONE 5:e15418. https://doi.org/10.1371/journal.pone.0015418
Tamošiūnė I, Stanienė G, Haimi P, et al (2018) Endophytic Bacillus and Pseudomonas spp. modulate apple shoot growth, cellular redox balance, and protein expression under in vitro conditions. Front Plant Sci 9. https://doi.org/10.3389/fpls.2018.00889
Tan RX, Zou WX (2001) Endophytes: a rich source of functional metabolites. Nat Prod Rep 18:448–459
Tian L, Zhou X, Ma L et al (2017) Root-associated bacterial diversities of Oryza rufipogon and Oryza sativa and their influencing environmental factors. Arch Microbiol 199:563–571. https://doi.org/10.1007/s00203-016-1325-2
Timm CM, Carter KR, Carrell AA, et al (2018) Abiotic stresses shift belowground populus-associated bacteria toward a core stress microbiome. mSystems 3. https://doi.org/10.1128/mSystems.00070-17
Travis AJ, Norton GJ, Datta S et al (2015) Assessing the genetic diversity of rice originating from Bangladesh, Assam and West Bengal. Rice 8:35. https://doi.org/10.1186/s12284-015-0068-z
van der Lelie D, Taghavi S, Monchy S et al (2009) Poplar and its bacterial endophytes: coexistence and harmony. CRC Crit Rev Plant Sci 28:346–358. https://doi.org/10.1080/07352680903241204
Vaughan DA (1994) The wild relatives of rice: a genetic resources handbook. Wild Relat rice a Genet Resour handbook
Vega FE, Pava-Ripoll M, Posada F, Buyer JS (2005) Endophytic bacteria in Coffea arabica L. J Basic Microbiol 45:371–380. https://doi.org/10.1002/jobm.200410551
Yoon SH, Ha SM, Kwon S et al (2017) Introducing EzBioCloud: a taxonomically united database of 16S rRNA gene sequences and whole-genome assemblies. Int J Syst Evol Microbiol 67:1613–1617. https://doi.org/10.1099/ijsem.0.001755
Zhang C, Kong F (2014) Isolation and identification of potassium-solubilizing bacteria from tobacco rhizospheric soil and their effect on tobacco plants. Appl Soil Ecol 82:18–25. https://doi.org/10.1016/j.apsoil.2014.05.002
Zhao L, Xu Y, Lai X-H et al (2015) Screening and characterization of endophytic Bacillus and Paenibacillus strains from medicinal plant Lonicera japonica for use as potential plant growth promoters. Brazilian J Microbiol 46:977–989. https://doi.org/10.1590/S1517-838246420140024
Acknowledgements
The authors are grateful to the Department of Biotechnology (DBT), Ministry of Science and Technology, Govt. of India for funding the research. The authors also kindly acknowledge the timely suggestions and encouragement received from Prof. M. K. Modi (Head, Department of Agricultural Biotechnology, AAU, Jorhat) and Professor B. K. Sarmah (Director, DBT-NECAB Centre, AAU, Jorhat) throughout the research work.
Funding
This study was funded by the Department of Biotechnology, Govt. of India (DBT, GoI), through the project entitled “Endophyte diversity” in wild versus cultivated rice across the environmental gradients in North East India (BT/PR15208/AGR/21/332/2011).
Author information
Authors and Affiliations
Contributions
MB had conceived and designed the study. MB had carried out the experiments and collected the data. MB, SD, SSB and RCB had analyzed the data. All the authors contributed equally in preparing the manuscript.
Corresponding author
Ethics declarations
Conflict of interest
The authors declare that they have no conflict of interest.
Ethical approval
This study involved a pot-experiment of wild-form bacterial isolates only.
Consent to participate
NA.
Consent for publication
No public participants were involved in this study. All the authors have given consent for publication.
Additional information
Communicated by Erko Stackebrandt.
Publisher's Note
Springer Nature remains neutral with regard to jurisdictional claims in published maps and institutional affiliations.
Supplementary Information
Below is the link to the electronic supplementary material.
Rights and permissions
About this article
Cite this article
Borah, M., Das, S., Bora, S.S. et al. Comparative assessment of multi-trait plant growth-promoting endophytes associated with cultivated and wild Oryza germplasm of Assam, India. Arch Microbiol 203, 2007–2028 (2021). https://doi.org/10.1007/s00203-020-02153-x
Received:
Revised:
Accepted:
Published:
Issue Date:
DOI: https://doi.org/10.1007/s00203-020-02153-x